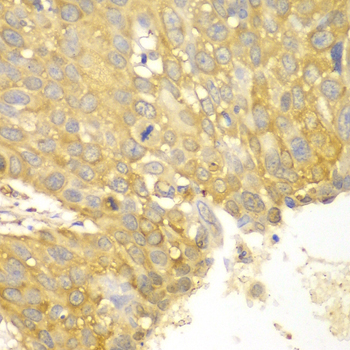

For quotations, please use our online quotation form, and you may also contact us by
service@kendallscientific.com
+1-888.733.6849 (Toll-free)
+1-617.299.7367 (Int’l))
+1-888.733.6849
Our customer service representatives are available 24 hours, Monday through Friday to assist you.| Reactivity | Human Mouse Rat |
| Tested applications | WB IHC |
| Recommended Dilution | WB 1:500 - 1:2000 IHC 1:50 - 1:200 |
| Calculated MW | 103kDa |
| Observed MW | Refer to Figures |
| Immunogen | Recombinant protein of human ACTN1 |
| Storage Buffer | Store at -20℃. Avoid freeze / thaw cycles. Buffer: PBS with 0.02% sodium azide, 50% glycerol, pH7.3. |
| Concentration | b |
| Synonym | ACTN1;FLJ40884;FLJ54432 ; |

Western blot analysis of extracts of various cell lines using ACTN1 antibody.
Immunohistochemistry of paraffin-embedded human lung cancer using ACTN1 antibody at dilution of 1:100 (400x lens).

Immunohistochemistry of paraffin-embedded human liver cancer using ACTN1 antibody at dilution of 1:100 (400x lens).

Immunohistochemistry of paraffin-embedded human esophageal using ACTN1 antibody at dilution of 1:100 (400x lens).

Immunohistochemistry of paraffin-embedded mouse heart using ACTN1 antibody at dilution of 1:100 (400x lens).
α-Actinin belongs to the spectrin family of cytoskeletal proteins. It was first recognized as an actin cross-linking protein, forming an antiparallel homodimer with an actin binding head at the amino terminus of each monomer. More recently, α-actinin has been shown to interact with a large number of proteins involved in signaling to the cytoskeleton including those involved in cellular adhesion, migration, and immune cell targeting (1). The interaction of α-actinin with intercellular adhesion molecule-5 (ICAM-5) helps to promote neurite outgrowth (2). In osteoblasts, interaction of α-actinin with integrins stabilizes focal adhesions and may protect cells from apoptosis (3). Isoforms 1 and 4 of α-actinin, which are non-muscle isoforms, are present in stress fibers, sites of adhesion and intercellular contacts, filopodia, and lamellipodia. The muscle isoforms 2 and 3 localize to the Z-discs of striated muscle and to dense bodies and plaques in smooth muscle (1).
N/A